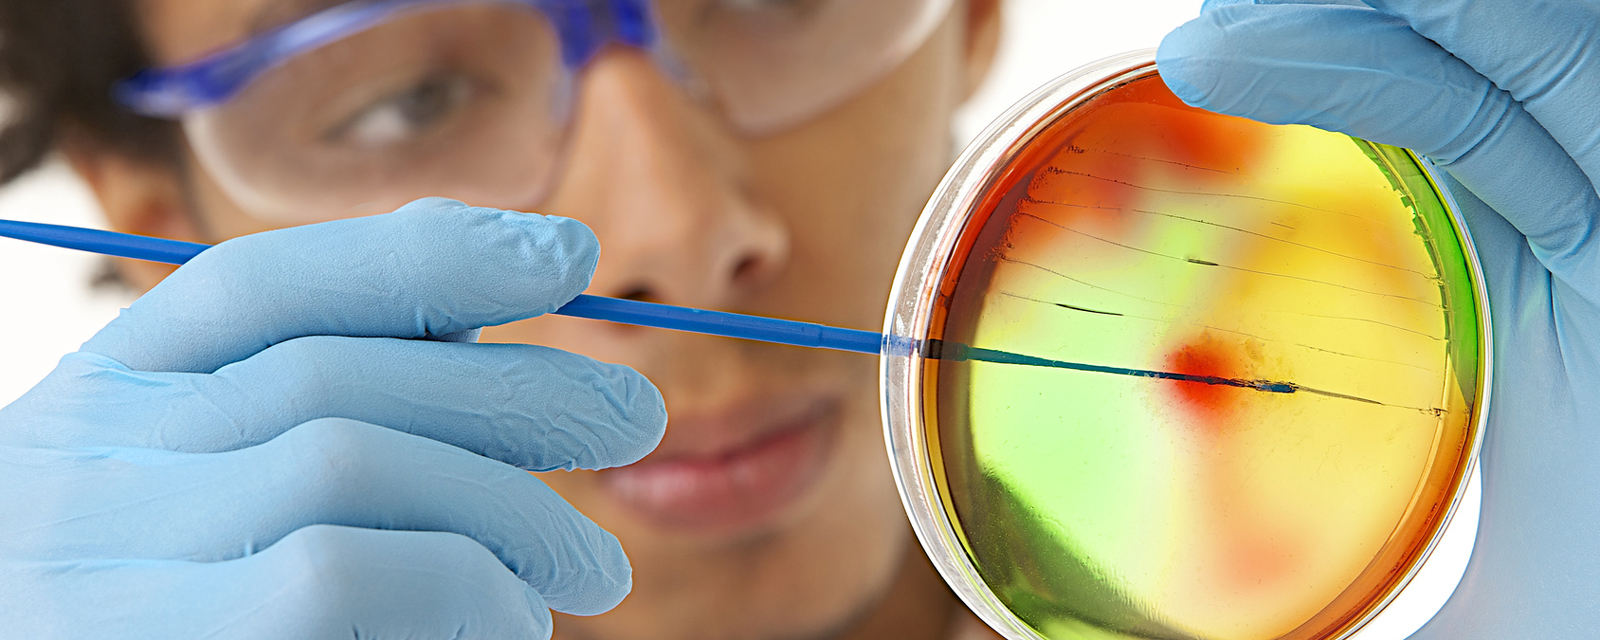
Visuel métier

- Choisir mon métier
- Recherche par nom
- Recherche par centre d'interêt
- Recherche par famille
- Recherche par compétence
- Choisir ma formation
- Rencontrer un pro
- Je suis une entreprise
- Je souhaite repérer des compétences
- Je souhaite former mes collaborateurs
- Où me former
- Agenda
- Infos Orientation

|
UN CONSEILLER À VOTRE ÉCOUTE |

PRÈS DE CHEZ VOUS |
|

TÉLÉCHARGER LE PDF |
|